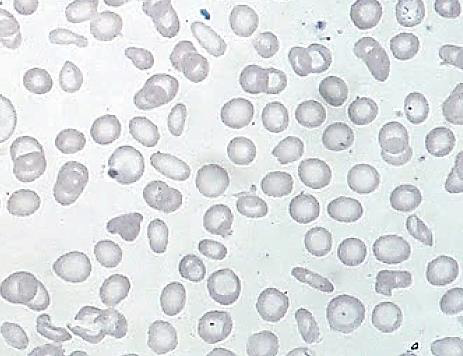
enunciado 1938125-1

“Ao analisar o esfregaço de sangue de uma paciente de 13 anos, notou-se anemia microcítica hipocrômica, hemácias em forma de lápis ou cigarro e anisositose.” Os resultados dos exames complementares dessa paciente e o esfregaço sanguíneo apresentam-se a seguir.

De acordo com os dados e as imagens anteriores, é correto afirmar que a paciente apresenta:
Provas
Questão presente nas seguintes provas